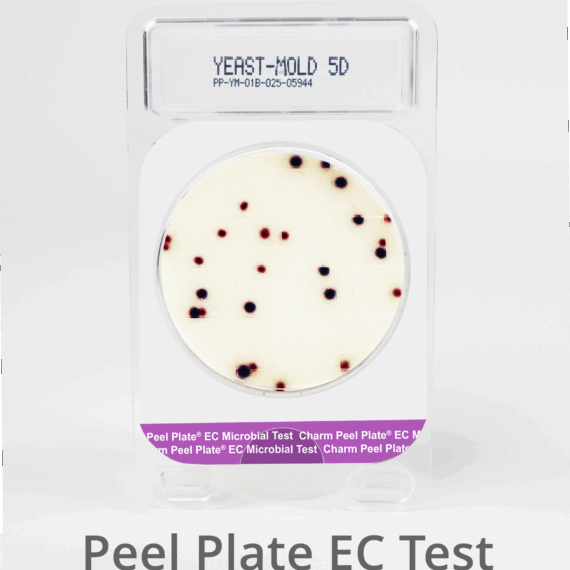

Peel Plate EC (E.coli y Coliformes)
Bs. 0.00Bs. 0.00
Peel Plate EC (E.coli y Coliformes)

Las pruebas microbianas Peel Plate EC difunden la muestra en medios que contienen agentes selectivos y tintes diseñados para la determinación de coliformes totales en productos lácteos cuando se incuban a 32 ° C. Cuando se incuba a 35 ° C, el método distinguirá E. coli de otros coliformes a través del color; E. coli son colonias de color azul / violeta, mientras que las de coliformes son rojas.reemplazo a placas Petrifilm.
Dado que los coliformes fermentan la lactosa, tienen la capacidad de descomponer el sustrato enzimático, salmon-gal, mediante la producción de β-galactosidasa, produciendo un color rojo. E. coli produce β-glucuronidasa que actúa sobre el x-glucurónido dando como resultado una colonia azul.
• Sensibilidad: >1 UFC/mL de muestra
• Rango Cuantitativo Preciso: 1 a 154 UFC / mL
• Incubación: 24 ± 2 horas a 35 °C +/- 1° (32°C para productos lácteos)
Procedimiento para Prueba Peel Plate EC
![]() |
Paso 1 • Para facilidad de uso las placas deben estar a temperatura ambiente. • Identifique la placa en el lado claro usando un marcador o una tira de código de barras. No marque o identifique la placa dentro del área circular de 47 mm. |
![]() |
Paso 2 • Invierta y aplique presión con los dedos en la plataforma trasera (como en la foto) y levante la tapa adhesiva. • Levante la cubierta adhesiva completamente hasta exponer el disco de cultivo.Deje la parte posterior adherida a la parte posterior de la placa. |
![]() |
Paso 3 • Manteniendo la cubierta levantada y la placa en una superficie plana, dispense verticalmente 1.0 mL de muestra en el centro del disco. Deposite muestra en 2 a 3 segundos y a 1-2cm arriba de la superficie. |
![]() |
Paso 4 • La muestra se difundirá a los bordes del disco. Para muestras viscosas puede mover la placa por rotación. • Re-aplique la cubierta adhesiva evitando dobleces o arrugas. Presione alrededor en la orilla para asegurarse del sellado apropiado. •Permita que el gel se asiente por 10 segundos antes de mover la placa. |
![]() |
Paso 5 • Incube las placas con la parte clara hacia arriba, como se muestra. • Incube a 35 ± 1 °C por 24 ± 2 horas para productos no lácteos, incluyendo agua, huevos líquidos, hisopos ambientales y carne. • Incube a 32 ± 1 °C por 24 ± 2 horas para leches y productos lácteos. • Hasta 20 placas pueden colocarse una sobre otra alineando las protuberancias y la plataforma rectangular. Esta configuración no afecta la transferencia de calor. |
Description
Peel Plate EC (E.coli y Coliformes)
El medio de la prueba Peel Plate EC está basado en el caldo EC para cultivar y diferenciar colorimétricamente el crecimiento de coliformes y E.coli en muestras cultivadas a 35 ± 1 °C. La prueba Peel Plate EC contiene el sustrato enzimático salmon-gal (6-cloro-3-indolyl-B-D- galactopiranosido) usado para detectar ß-galactosidasa producida por coliformes yx-glucuronido (5-bromo-4cloro-3-indoil-B-D-glucuronido) usado para detectar ß-glucuronidasa producida por E.coli cuando la muestra es incubada a 35 ± 1 °C. La prueba Peel Plate EC también contiene agentes gelificantes y absorbentes que permiten absorber y difundir la muestra, reemplazo a placas Petrifilm.
Aplicabilidad
La prueba Peel Plate EC a sido certificada por el Instituto de Investigación AOAC como PerformanceTest Method # 061501. El rendimiento de este kit de prueba fue revisado por AOAC-RI y se encontró que funciona según las especificaciones del fabricante. A 35 ± 1°C, la prueba Peel Plate EC ha sido validada para distinguir coliformes de E.coli en carne molida, esponjas de superficie ambiental, enjuague de canales y esponjas, y agua filtrada de 0,45μm de proceso de vegetales/frutas, y no se encontró una diferencia significativa de los métodos de referencia oficiales FDA-BAMoUSDA-FSISoEPA. A 32 ± 1°C, el método ha sido validado para la detección de coliformes totales en lácteos líquidos (leche cruda y pasteurizada, descremada,chocolate,nata),lácteos sólidos(leche desnatada en polvo reconstituida, lactosa reducida, helado de vainilla, condensada/evaporada, con otro sabor)y no se encontró diferencia significativa al método de referencia Agar Violet Red Bile Agar(VRBA) con colonias confirmadas con caldo Brilliant Green Lactose Bile(BGLB).Las muestras deben diluirse en serie para obtner rango contable de 1a154UFC/ml.